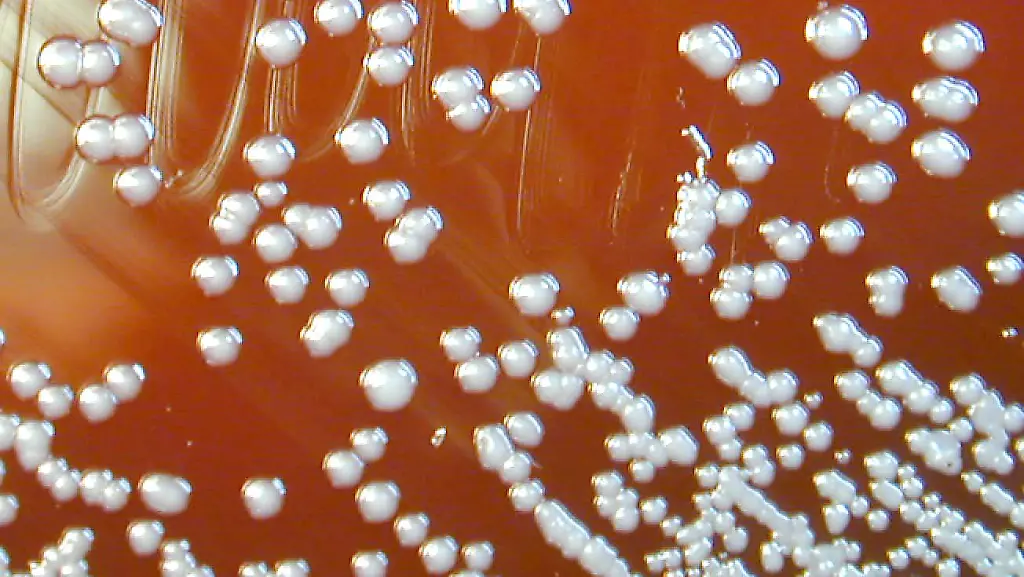
Burkholderia-pseudomallei-01

Verbreiteter als bisher gedachtMelioidose ist so gefährlich wie Masern
Kaum jemand hat hierzulande je von Melioidose gehört. Dabei sterben an der Infektion jedes Jahr rund 90.000 Menschen weltweit. Die Krankheit, die auch Pseudo-Rotz genannt wird, ist bisher in 45 Ländern bekannt. Weitere könnten folgen.
Eine gefährliche, Tuberkulose-ähnliche Erkrankung ist nach einer neuen Analyse weit häufiger und in weit mehr Ländern verbreitet als bisher angenommen. Die sogenannte Melioidose verursache weltweit fast 90.000 Todesfälle pro Jahr, fast so viele wie die Masern und weit mehr als das Dengue-Fieber, kalkulieren Wissenschaftler im Fachmagazin "Nature Microbiology". Das Ausmaß sei bisher auch darum massiv unterschätzt worden, weil die Tropenkrankheit schwer zu diagnostizieren sei. Die Erkrankung ist in Deutschland nicht meldepflichtig, vereinzelt werden aber auch hierzulande immer wieder von Reisenden eingeschleppte Fälle bekannt.
Die Melioidose wird auch Pseudo-Rotz genannt. Die Infektion wird vom Bodenbakterium Burkholderia pseudomallei verursacht, das ursprünglich in Südostasien und Nordaustralien gefunden wurde. Über infizierte Tiere kann es sich jedoch in neuen Gebieten ausbreiten. Die Symptome sind vielfältig – was ein weiterer Grund für die schwierige Diagnose ist. Bei akuten Formen sind Lungenabszesse und Lungenentzündungen häufig – diese Beschwerden ähneln denen der Tuberkulose. Zudem gibt es chronische Verläufe, meist mit Abszessen an anderen Organen wie Milz oder Leber.
Keine Impfmöglichkeit
Eine zugelassene Schutzimpfung existiert bisher nicht. Ein großes Problem sei zudem, dass das Bakterium gegen eine Vielzahl von Antibiotika resistent ist, heißt es in "Nature Microbiology". Selbst bei einer Behandlung könne die Todesrate daher bei über 70 Prozent liegen, wenn nicht mit bestimmten Präparaten und langanhaltend therapiert werde.
Die Wissenschaftler um Direk Limmathurotsakul von der Universität Oxford werteten mehr als 22.000 erfasste Melioidose-Fälle bei Tieren und Menschen sowie Nachweise von B. pseudomallei in der Umwelt zwischen 1910 und 2014 aus. Das Team geht von derzeit rund 165.000 Infektionen jährlich weltweit aus, von denen etwa 89.000 tödlich verlaufen. Fast alle Todesfälle entfallen demnach auf Länder mit geringen oder mittleren Einkommen. Zum Vergleich: An Masern sterben geschätzt knapp 96.000 Menschen jährlich, an Dengue-Fieber bis zu 12.500.
Erreger in immer mehr Ländern nachweisbar
Die Hochrechnung lässt zudem darauf schließen, dass die Zahl der Fälle in den 45 Ländern, in denen die Krankheit bekanntermaßen dauerhaft vorkommt, erheblich unterschätzt wird. Zudem sei der Erreger möglicherweise bereits in 34 weiteren Ländern heimisch, ohne bisher nachgewiesen geworden zu sein. Erst kürzlich sei der Erreger beispielsweise in Indien, dem südlichen China. Brasilien und Malawi entdeckt worden. Auch in den USA und Japan gebe es Regionen mit günstigen Umweltbedingungen für B. pseudomallei – möglicherweise komme das Bakterium auch dort schon vor.
Die Hochrisikozonen lägen aber in Südostasien, Südasien und dem tropischen Australien sowie im Westen Afrikas südlich der Sahara und in Südamerika, heißt es in der Studie weiter. Rund drei Milliarden Menschen lebten in Regionen, in denen B. pseudomallei wahrscheinlich vorkomme. Der Krankheit müsse von Gesundheitsorganisationen und der Politik dringend mehr Aufmerksamkeit gewidmet werden, betonen die Forscher. Nötig seien etwa Informationskampagnen und bessere Behandlungsrichtlinien.
Ansteckung über kleine Wunden
Für die Landbevölkerung sei nach derzeitigem Stand die Aufnahme des Erregers durch kleine Wunden in der Haut der häufigste Übertragungsweg, erläutert das internationale Team. Erst seit Kurzem gebe es Hinweise, dass das Bakterium vor allem bei Extremwetterlagen auch über die Atemwege ansteckend ist. Ein weiterer wichtiger Infektionsweg sei kontaminiertes Wasser. Besonders groß sei das Erkrankungsrisiko bei Menschen mit Diabetes, chronischen Nierenerkrankungen oder hohem Alkoholkonsum.
Im Zuge des zunehmenden Reise- und Urlaubsverkehrs weltweit werden auch in Ländern immer mehr Melioidose-Diagnosen gestellt, in denen der Erreger nicht im Boden vorkommt. Das sei auch für Deutschland anzunehmen, sagt Roland Grunow vom Robert Koch-Institut (RKI) in Berlin. Da die Krankheit hierzulande anders als in den betroffenen Regionen vielen Hausärzten kaum bekannt sei, dauere es mitunter bis zu einer Diagnose einige Zeit, wenn sie überhaupt gestellt werde. Erschwerend komme hinzu, dass zwischen Ansteckung und Ausbruch oder Wiederauftreten der Krankheit bei chronisch-rezidivierenden Verläufen eine Zeitspanne von Monaten bis Jahren liegen könne. "Deshalb kann es dazu kommen, dass dann erst einmal nicht an die Möglichkeit einer Tropenkrankheit gedacht wird."
In "Nature Microbiology" nennen die Forscher einen größeren Ausbruch in Paris 1975 als Beispiel für die Einschleppung des Erregers. Zwei Menschen und eine unbekannte Zahl von Tieren seien damals gestorben, das Bakterium habe sich noch jahrelang im Boden gehalten.
Ende 2014 war der Erreger aus einem Hochsicherheitslabor des Tulane National Primate Research Center im US-Bundesstaat Louisiana entwichen, weil sich Rhesusaffen in Außengehegen mit ihm infiziert hatten. In Boden- und Wasserproben vom Gelände der Einrichtung seien die Bakterien nicht nachzuweisen, gaben die Behörden schließlich Entwarnung.